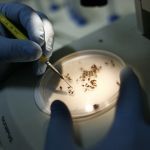
Dengue pode elevar em 17 vezes risco de síndrome de Guillain-Barré

Paula Arantes
Formada em Jornalismo pela Puc Minas, Paula Arantes produziu inicialmente conteúdos para as editorias Minas Gerais, Brasil, Mundo, Orações e Entretenimento no portal da Itatiaia. Atualmente, colabora com a editoria Meio Ambiente. Antes, passou pelo jornal Estado de Minas.